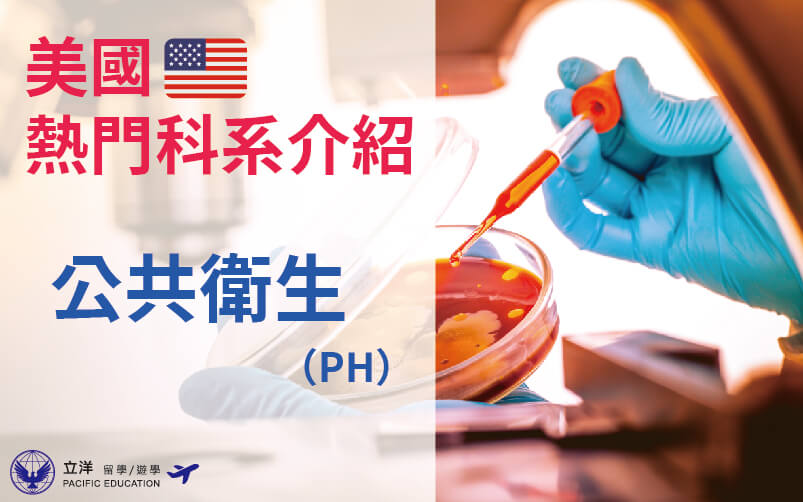

科系介紹

20
Jan
2022
【美國】熱門科系介紹-專案管理(Project Management,PJM)
more

20
Jan
2022
【美國】熱門科系介紹-音樂(Music)
more

17
Jan
2022
【美國】熱門科系介紹-社工(Social Work)
more

17
Jan
2022
【美國】熱門科系介紹-材料工程(Materials Engineering)
more

14
Jan
2022
【美國】熱門科系介紹-會計(Accounting)
more

14
Jan
2022
【美國】熱門科系介紹-護理(Nursing)
more

13
Jan
2022
【美國】熱門科系介紹-化學工程(Chemical Engineering)
more

13
Jan
2022
【美國】熱門科系介紹-經濟學(Economics)
more

10
Jan
2022
【美國】熱門科系介紹-生物科學(Biological Science)
more

27
Dec
2021
【美國】熱門科系介紹-法學碩士(Legum Magister,LL.M.)
more
24
Dec
2021
【美國】熱門科系介紹-公共衛生(Public Health,PH)
more

23
Dec
2021
【美國】熱門科系介紹-教育-課程設計(Education-Curriculum and Instruction,C&I)
more
